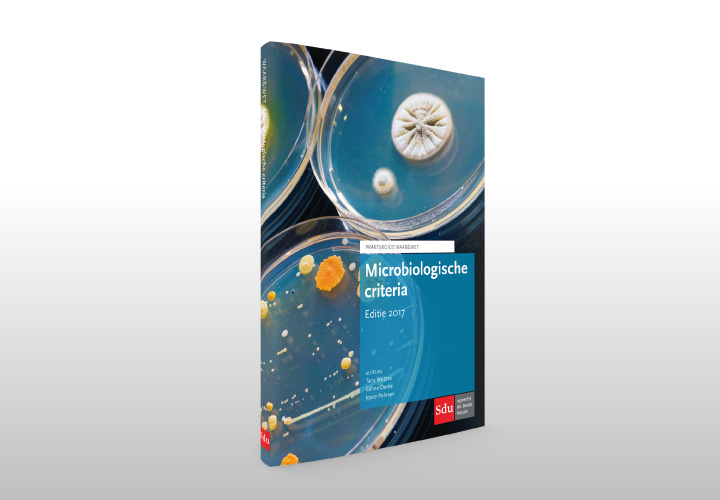

Praktijkgidsen Warenwet
Praktijkgidsen Warenwet
Ontwerp:
Omslag
In opdracht van:
Sdu uitgevers bv, Den Haag
Hebt u te maken met de nieuwe Europese levensmiddelenregelgeving? En zoekt u een handzame leidraad die u helpt effectief aan de slag te gaan? Dan vallen de uitgaven uit de reeks Praktijkgidsen Warenwet beslist bij u in de smaak!
- Voedings- en gezondheidsclaims
- HACCP:gevaren- en risicoanalyse
- De Europese hygiëneverordeningen
- Voedselcontactmaterialen
- Allergenen
- Additieven in levensmiddelen
- Microbiologische criteria
- Consumenteninformatie en etikettering van levensmiddelen
- De Claimsverordening
- Landkaart Levensmiddelenrecht
- Productverantwoordelijkheid voor levensmiddelen